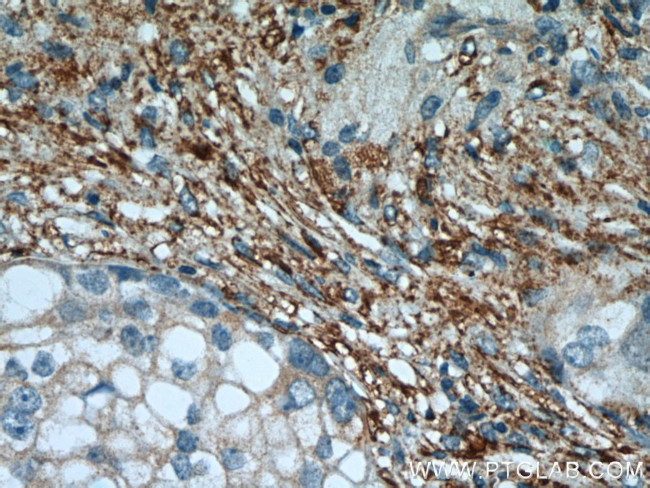
PPP2R1A Antibody in Immunohistochemistry (Paraffin) (IHC (P))
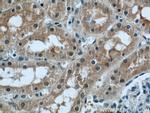
PPP2R1A Antibody in Immunohistochemistry (Paraffin) (IHC (P))

Search
Proteintech
PPP2R1A Polyclonal Antibody
{{$productOrderCtrl.translations['antibody.pdp.commerceCard.promotion.promotions']}}
{{$productOrderCtrl.translations['antibody.pdp.commerceCard.promotion.viewpromo']}}
{{$productOrderCtrl.translations['antibody.pdp.commerceCard.promotion.promocode']}}: {{promo.promoCode}} {{promo.promoTitle}} {{promo.promoDescription}}. {{$productOrderCtrl.translations['antibody.pdp.commerceCard.promotion.learnmore']}}
产品信息
15882-1-AP
种属反应
已发表种属
宿主/亚型
分类
类型
抗原
偶联物
形式
浓度
规格
纯化类型
保存液
内含物
保存条件
运输条件
产品详细信息
Immunogen sequence: DLEALVMPT LRQAAEDKSW RVRYMVADKF TELQKAVGPE ITKTDLVPAF QNLMKDCEAE VRAAASHKVK EFCENLSADC RENVIMSQIL PCIKELVSDA NQHVKSALAS VIMGLSPILG KDNTIEHLLP LFLAQLKDEC PEVRLNIISN LDCVNEVIGI RQLSQSLLPA IVELAEDAKW RVRLAIIEYM PLLAGQLGVE FFDEKLNSLC MAWLVDHVYA IREAATSNLK KLVEKFGKEW AHATIIPKVL AMSGDPNYLH RMTTLFCINV LSEVCGQDIT TKHMLPTVLR MAGDPVANVR FNVAKSLQKI GPILDNSTLQ SEVKPILEKL TQDQDVDVKY FAQEALTVLS LA (239-589 aa encoded by BC001537)
靶标信息
The PR65 subunit of protein phosphatase 2A serves as a scaffolding molecule to coordinate the assembly of the catalytic subunit and a variable regulatory B subunit. Upon interaction with GNA12 promotes dephosphorylation of microtubule associated protein TAU/MAPT. Required for proper chromosome segregation and for centromeric localization of SGO1 in mitosis.
仅用于科研。不用于诊断过程。未经明确授权不得转售。
生物信息学
蛋白别名: alpha isoform of regulatory subunit A, protein phosphatase 2; Medium tumor antigen-associated 61 kDa protein; MGC786; PP2A subunit A isoform PR65-alpha; PP2A subunit A isoform R1-alpha; PP2Aa; PP2Ac; PP2CA; PP2Calpha; PPP2R1A; protein phosphatase 2 (formerly 2A), regulatory subunit A (PR 65), alpha isoform; protein phosphatase 2 (formerly 2A), regulatory subunit A, alpha isoform; protein phosphatase 2, regulatory subunit A, alpha; protein phosphatase PP2A; RP-C; serine/threonine protein phosphatase A subunit type 2A; Serine/threonine-protein phosphatase 2A 65 kDa regulatory subunit A alpha isoform; testicular secretory protein Li 1; unnamed protein product
基因别名: 6330556D22Rik; HJS2; MRD36; PP2A; PP2A-Aalpha; PP2AA; PP2AAALPHA; PPP2R1A; PR65; PR65A
UniProt ID: (Human) P30153, (Mouse) Q76MZ3
Entrez Gene ID: (Human) 5518, (Mouse) 51792, (Rat) 117281